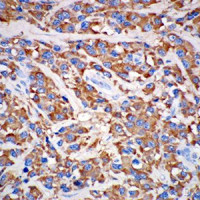
免疫组化-IHC

万千商家帮你免费找货
0 人在求购买到急需产品
- 详细信息
- 询价记录
- 技术资料
- 服务名称:
电镜
- 提供商:
MDL-百奥思科
透射电镜实验
常用的方法
超薄切片法、冷冻超薄切片法、冷冻蚀刻法、冷冻断裂法等。对于液体样品,通常是挂预处理过的铜网上进行观察。
扫描电镜技术服务
扫描电镜主要用二次电子观察形貌,在扫描电镜中,电子枪发射出来的电子束,经三个电磁透镜聚焦后,成直径为几个纳米的电子束。
扫描电镜取材要求
由于电镜电子束穿透能力的限制,必须把标本切成厚度小于0.1um以下的薄片才适用,这种薄片称为超薄切片。常用的超薄切片厚度是50-70nm。 在透射电镜的样品制备方法中,超薄切片技术是最基本、最常用的制备技术。
-----------------------------------------------------------------------------------------------------------------------------------------
MDL让科研更简单!
MDL为您提供科研CRO一站式服务,方案评估、方案设计、方案执行、报告整理以及后续SCI写作与发表等,全程实验技术服务。MDL自有实验室超过6000平米。聚焦基础科研、动物模型、细胞模型、组学服务、生物信息学、基因检测、细胞增殖、细胞周期凋亡、细胞培养、病毒包装,稳定株筛选、原代细胞分离、流式检测、平板克隆、划痕、侵袭迁移、WB、蛋白抽提、蛋白定量、蛋白质纯化、蛋白双向电泳、明胶酶谱、定量pcr、荧光定量PCR服务、包埋切片爬片、免疫组化、免疫荧光等医学科学基础研究与转化医学的研究。08年至今我们与科研人员共同完成12000+课题。在课题设计、课题执行、试剂采购、动物造模、标本检测、报告整理以SCI科研文章指导投稿等方面积累了丰富的经验。用户可以参与实验,实验过程中有任何疑问,我们均提供免费技术支持,欢迎来我公司参观考查。



MDL是北京百奥思科生物医学技术有限公司持有
服务热线:010-80842119
实验室地址:肽谷生物医药产业园A7号楼
公司网址:http://www.mdlbiotech.com/
服务邮箱:market@mdlbiotech.com
风险提示:丁香通仅作为第三方平台,为商家信息发布提供平台空间。用户咨询产品时请注意保护个人信息及财产安全,合理判断,谨慎选购商品,商家和用户对交易行为负责。对于医疗器械类产品,请先查证核实企业经营资质和医疗器械产品注册证情况。
- 作者
- 内容
- 询问日期
技术资料暂无技术资料 索取技术资料